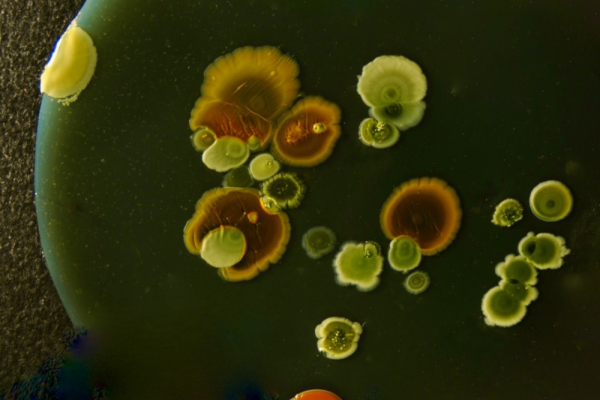
Photo by GUY GRANDJEAN on Unsplash Photo

Thursday, May 28, 2026 6:00 PM to 7:00 PM
36.0971467, -80.2451936
About
Join NCMA Winston-Salem for an exclusive trip to Culture WS, a one-of-a-kind arts hub in the heart of downtown Winston-Salem. Located in a 14,000 sq. ft. former corporate office, Culture WS is an eclectic, welcoming space with 35 artist studios, expansive gallery walls, and intimate gathering areas that invite connection and inspiration.
This Field Trip coincides with Culture WS's Collage Night. Attendees can participate in artist demonstrations and explore the studios of local photographers, painters, tattoo artists, and musicians. Experience a vibrant space rooted in creativity and engage directly with the artist who bring it to life.
Culture WS
Culture is a thriving community art and studio space on the 9th floor of the Liberty Plaza in downtown Winston Salem. Founded in 2022, Culture boasts 32 studios dedicated to artists and hosts regular events open to the public. Collage Night is our most popular event, running for over three years and drawing a wide attendance.